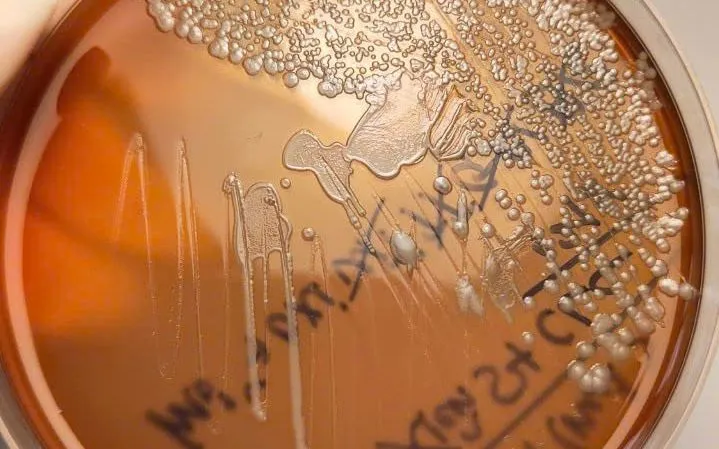

Hình ảnh vi khuẩn Burkholderia pseudomallei trên môi trường nuôi cấy.
Bệnh nhân là người dân tộc thiểu số, sống ở vùng nông thôn, thường xuyên tiếp xúc với đất và nước bẩn - môi trường thuận lợi để vi khuẩn tồn tại và lây nhiễm.
Theo các bác sĩ, Whitmore là bệnh truyền nhiễm nguy hiểm do vi khuẩn Burkholderia pseudomallei gây ra, thường có trong đất, bùn, nước tù đọng, ao hồ, ruộng lúa. Vi khuẩn có thể xâm nhập vào cơ thể qua vết trầy xước da, đường hô hấp hoặc tiêu hóa.
Những người có vết thương hở, người mắc bệnh mạn tính như đái tháo đường, bệnh phổi, gan, suy giảm miễn dịch và người dân vùng nông thôn, miền núi là nhóm có nguy cơ cao.
Bệnh có thể gây nhiễm trùng da, áp xe, viêm phổi, nhiễm khuẩn huyết và đe dọa tính mạng nếu không được phát hiện và điều trị sớm.
Các chuyên gia khuyến cáo, Whitmore không phải bệnh mới, song rất nguy hiểm nếu chủ quan. Người dân cần giữ vệ sinh cá nhân, tránh tiếp xúc trực tiếp với đất, nước bẩn khi có vết thương hở, đồng thời đến ngay cơ sở y tế khi có dấu hiệu nhiễm trùng để được chẩn đoán và điều trị kịp thời.













